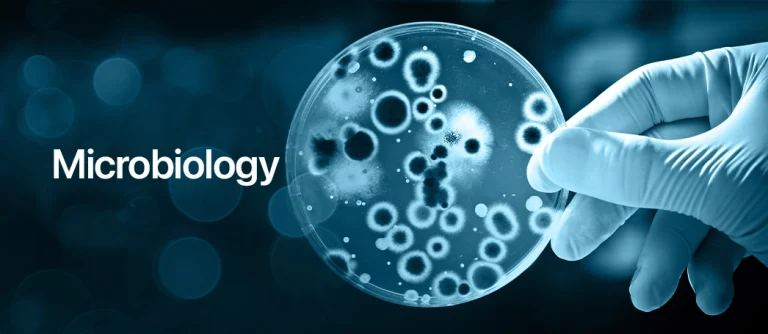

The Doctor of Philosophy (Ph.D.) in Microbiology is an intensive research-based programme aimed at developing high-level expertise in microbial sciences. It equips scholars with the advanced skills needed to conduct original research, contribute to scientific literature, and solve global challenges in health, food safety, and environmental sustainability. The programme nurtures independent, critical thinkers who can innovate in academia, industry, and policy-making.
The Ph.D. Microbiology programme offers three major specialization areas:
Medical Microbiology & Parasitology
Advanced study of human and animal pathogens, immune system interactions, and infectious disease control.
Topics include high-level bacteriology, virology, parasitology, molecular diagnostics, immunology, epidemiology, antimicrobial resistance, and vaccine innovation.
Food & Dairy Microbiology
Focuses on the microbiology of food systems, quality control, and biotechnology applications in food production.
Covers foodborne pathogen genomics, advanced HACCP systems, probiotic research, and novel food safety technologies.
Environmental Microbiology
Investigates the roles of microorganisms in ecosystems and their use in sustainable environmental solutions.
Includes microbial ecology, metagenomics, climate change microbiology, and advanced bioremediation techniques.
AWARD TITLE
Ph.D
START DATE
September 2026
DURATION
3 years
STUDY MODE
Full-time
CAMPUS
Nigeria, Lokoja
Learning Methods:
Independent and supervised research under expert guidance
Doctoral seminars and workshops
Teaching and mentoring of undergraduate students (where applicable)
Field and laboratory-based investigations
Participation in national and international scientific conferences
Assessment Structure:
Comprehensive research thesis defended before an academic panel
Peer-reviewed publications in reputable journals
Oral examinations and progress reviews
Seminar presentations and research proposals

Advanced Microbial Research Techniques: Cutting-edge methods for microbial detection, analysis, and genetic manipulation.
Microbial Genomics and Bioinformatics: In-depth study of microbial genomes, metagenomics, and computational analysis.
Specialized Medical Microbiology: Advanced investigation into pathogens, host responses, and novel diagnostic approaches.
Advanced Parasitology and Mycology: Focuses on emerging pathogens, resistance mechanisms, and disease control strategies.
Innovations in Food Microbiology: Research into functional foods, fermentation technologies, and microbial quality control.
Environmental Microbial Biotechnology: Studies bioremediation, microbial fuel cells, and climate-related microbial adaptations.
Scientific Writing and Grant Proposal Development: Trains scholars in preparing research manuscripts and competitive funding applications.
Doctoral Research Seminar Series: Regular presentation and peer review of ongoing research work.
Ph.D. graduates can work as:
University professors and academic researchers
Senior scientists in biotechnology, pharmaceuticals, and food industries
Public health policy advisors
Lead microbiologists in environmental agencies and NGOs
Research directors in private and government laboratories


An M.Sc. degree in Microbiology or a closely related discipline with a strong research background.
Evidence of academic publications is an added advantage.
A well-developed research proposal aligned with one of the specialization areas.
Successful performance at the admission interview.
Candidates applying for admission into the postgraduate programme shall satisfy the general University requirements in addition to providing the following:
National Identification Number (NIN)
The course fees you’ll pay and the funding available to you depends on factors such as your nationality, location, personal circumstances and the course you are studying. Visit the links below and scroll down to find the Postgraduate section.
Find out about grants, bursaries, scholarships and living costs in our postgraduate taught fees and funding section.
Our alumni are breaking boundaries and redefining success. Read their stories and get inspired to start your own journey.
Take the first step towards your academic future at Salem University